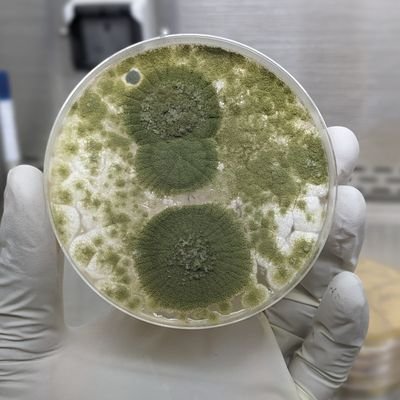
AkyooJonathan's profile picture. 🇹🇿 Medical Laboratory Technologist
NTDs researcher (Onchocerciasis and Lymphatic filariasis)

bugbitten
@bugbittentweets
Official Twitter account for open access @BioMedCentral journal Parasites & Vectors and its official blog BugBitten
قد يعجبك
Did you know that BugBitten has moved to Springer Nature's Research Communities? Find us here: communities.springernature.com/badges/bugbitt…
Mosquitoes are NOT vectors of Lyme disease virus - a study in Parasites & Vectors has proven through experimental work that mosquitoes are not vectors of the virus that causes Lyme disease communities.springernature.com/posts/the-vect…
communities.springernature.com
The Vector Verdict: Mosquitoes Acquitted!
Lyme disease is a tick-borne disease prevalent across Europe and the US. Many patients however, do not recall a tick bite, leaving people wondering whether other arthropods like mosquitoes could be...
Can you 'vaccinate' soils to protect against nematodes? The soil microbiome then takes on the role of the 'immune system' #worldmicrobiomeday communities.springernature.com/posts/guardian…
communities.springernature.com
Guardians of the earth: can the soil be ‘vaccinated’ to protect against nematode pathogens?
Adding nematode collagen and chitin to soils could shape the microbiome, selecting for those microbes with the ability to fight these pathogen
Our latest blog from BugBitten looks to the future - Empowering the next generation of biologists with One Health skills... by @BiteOfAMosquito communities.springernature.com/posts/empoweri…
communities.springernature.com
Empowering the next generation of biologists with One Health skills and principles into an uncert...
Krisztian Magori summarizes the One Health-related research projects that students in his Disease Ecology Senior Capstone class completed this Spring quarter, demonstrating their work ethic and...
European Scientific Counsel Companion Animal Parasites (ESCCAP) Launches Parasite Infection Maps esccap.org/parasite-infec… @ESCCAP
"🗨️What species are the predicative signatures of noma? "🧬 — Stuart Ainsworth, University of Liverpool 🧫 At #MSFsci: Exploring the microbial landscape of noma through deep shotgun metagenomics — a first-of-its-kind study from Nigeria’s Noma Children’s Hospital. 🧠 Stuart…

“I am sure this is only the tip of the tip of the iceberg” 🧬 — Ivo Steinmetz from @MedUniGraz 🚨 Now at #MSFsci: Uncovering a hidden threat? Ivo Steinmetz presents research on paediatric melioidosis cases in Mali — raising the question: is this just the tip of the iceberg for…

#MSFsci released 8 million mosquitoes infected with wolbachia with help from the community in Honduras. 95% of the Aedes egypti mosquito population is infected with wolbachia
#MSFsci wolbachia control of dengue mosquitoes. It can be a one time application method, as it can be passed through mosquito generations

🗨️ “We had to let go of some of our learning goals and really focus on what was needed by our operations” 🎤Janet Ousley from @MSF discusses how research should and can be flexible through her presentation on tackling schistosomiasis in South Sudan🌍🏥 #MSFsci…

#MSFsci schistomiasis is a serious disease. The SCAPA program gave praziquantil to anyone presenting with clinical symptoms in South Sudan.

“It is vital that organisations like @MSF and @gavi work together to reach the most vulnerable and the most neglected”— MSF UK General Director 🚀 Kicking off #MSFScientificDay 2025 with opening remarks from MSF UK General Director, Natalie Roberts! Setting the tone for a day…
Schistosomiasis is one of the topics that will be discussed at MSF Scientific Days next week @MSFsci read this recent paper from Parasites & Vectors on the discovery of 2 new antischistosomal compounds parasitesandvectors.biomedcentral.com/articles/10....

@bugbittentweets Oxitech and anopheles in the news. GM mosquitoes: inside the lab breeding six-legged agents in the war on malaria theguardian.com/global-develop…
Interesting free webinar run by @ESCCAP - Parasites on the move in Europe: which novel parasite is coming to a consulting room table near you? Nov 12th thewebinarvet.com/events/parasit…
Just published: Do I drink your blood or not? communities.springernature.com/posts/do-i-dri…
communities.springernature.com
Do I drink your blood or not? A mosquito’s dilemma
Aedes mosquitoes and Anopheles mosquitoes decide whether to take a blood meal based on chemicals in your blood.
We are happy to announce that the KT Jeang Retrovirology Prize for 2024 has been awarded to Walther Mothes Read about his work and accomplishments here: retrovirology.biomedcentral.com/articles/10.11…

New in Retrovirology: Endogenous feline leukemia virus long terminal repeat integration site diversity is highly variable in related and unrelated domestic cats by Chiu et al. Read now at: retrovirology.biomedcentral.com/articles/10.11…

United States الاتجاهات
- 1. #SurvivorSeries 151K posts
- 2. Auburn 23.9K posts
- 3. Austin Theory 2,469 posts
- 4. Bama 20.9K posts
- 5. Seth 19.1K posts
- 6. Roman 44.6K posts
- 7. Liv Morgan 29.5K posts
- 8. Ty Simpson 2,315 posts
- 9. Vandy 17.5K posts
- 10. Duke 21.1K posts
- 11. Nikki 35.8K posts
- 12. John Cena 32.9K posts
- 13. Preston Howard N/A
- 14. Bron Breakker 3,441 posts
- 15. Jovic 1,258 posts
- 16. Punk 32.3K posts
- 17. Brock Lesnar 5,663 posts
- 18. #IronBowl 1,187 posts
- 19. Miami 101K posts
- 20. Ryan Williams N/A
قد يعجبك
-
 Malaria Journal
Malaria Journal
@MalariaJournal -
 Trends in Parasitology
Trends in Parasitology
@TrendsParasitol -
 Bloodsucking Parasites
Bloodsucking Parasites
@bloodSparasites -
 Parasitology
Parasitology
@JnlParasitology -
 Aust Soc for Para
Aust Soc for Para
@AS_Para -
 ASP-Parasitologists
ASP-Parasitologists
@AmSocParasit -
 Parasite - The Journal
Parasite - The Journal
@ParasiteJournal -
 Tropical Medicine and Infectious Disease MDPI
Tropical Medicine and Infectious Disease MDPI
@TropicalmedMDPI -
 Reif Research Lab 🕷👩🔬🐮🐶
Reif Research Lab 🕷👩🔬🐮🐶
@ReifLab -
 IVCC
IVCC
@invectorcontrol -
 MalariaAtlasProject
MalariaAtlasProject
@MalariaAtlas -
 ISNTD
ISNTD
@ISNTD_Press -
 Russell Stothard
Russell Stothard
@StothardRuss -
 MESA - the malaria knowledge hub
MESA - the malaria knowledge hub
@MESAmalaria
Something went wrong.
Something went wrong.